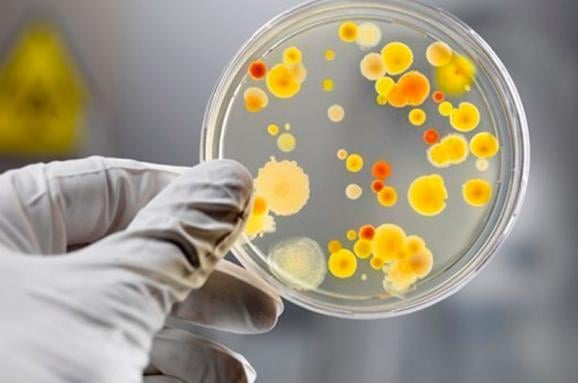

У середу, 23 вересня, зареєстрований груповий осередок гострої кишкової інфекції в їдальні ТОВ «Фабрика їжі» на заводі «ЛЕОНІ» в Коломиї.
В результаті потерпіло 194 особи (працівники заводу), з них 54 знаходились на стаціонарному лікуванні в лікувальних закладах області, інформує Фіртка з посиланням на Головне управління Держпродспоживслужби в області.
Харчування працівників заводу здійснює ТОВ «Фабрика їжі».
При перших зверненнях хворих до лікувальних закладів керівництво ТОВ «Фабрика їжі» звернулося до Головного управління Держпродспоживслужби в Івано-Франківській області щодо проведення санітарно-епідеміологічного розслідування для встановлення причин захворювання.
Їдальня ТОВ «Фабрика їжі» розміщена на території заводу ТзОВ «Леоні Ваерінг Системс УА ГмбХ» і харчує працівників заводу у три зміни, яким напередодні пропонується три види меню.
Спеціалістами Коломийського міського управління Головного управління Держпродспоживслужби в Івано-Франківській області проведено санітарно-епідеміологічне обстеження їдальні підприємства, за результатами якого проведений позаплановий захід державного контролю у сфері безпечності харчових продуктів. При проведені даних заходів здійснено відбір води, харчових продуктів, сировини, з яких готувалися страви. Відібрано змиви з обладнання, інвентарю, посуду, виробничих столів, одягу та рук працівників харчоблоку.
В результаті проведених заходів та лабораторних досліджень виявлено перевищення вмісту КМАФАнМ в курячому суповому наборі, в змивах з об’єктів навколишнього середовища виявлено БГКП та незначні порушення в їдальні: не заповнений журнал бракеражу сирої продукції, відсутня фіксація часу і дати прибирання у письмовому вигляді, частково стерто маркування на окремих виробничих столах. Дані невідповідності не є визначальними та не могли викликати захворювання людей.
За наслідками перевірки спеціалістами Держпродспоживслужби:
- - тимчасово призупинено роботу їдальні ТзОВ «Леоні Ваерінг Системс УА ГмбХ» ТОВ «Фабрика їжі»;
- - видано приписи ТОВ «Фабрика їжі» на усунення виявлених невідповідностей;
- - видано припис ПП Мостовому А.М. щодо необхідності запровадження системи НАССР.;
- - вилучено залишки харчових продуктів: філе курячого 62 кг, риби мороженої (хека) 2 кг;
- - тимчасово відсторонено від роботи 3 працівників.
Медичними працівниками проведені заходи щодо ідентифікації збудника (S enteritidis), який викликав захворювання серед працівників ТзОВ «Леоні Ваерінг Системс УА ГмбХ» та працівників харчоблоку. Виявлено 25 підтверджених випадків сальмонельозу у захворілих та 3 працівників харчоблоку.
За результатами розслідування встановлено, що ймовірною причиною спалаху могло стати вживання забрудненого харчового продукту S enteritidis (сальмонела), внаслідок безсимптомного бактеріоносійства.
У вівторок, 6 жовтня, спеціалістами Коломийського міського управління Головного управління Держпродспоживслужби в Івано-Франківській області проведено позаплановий захід державного контролю в ТОВ «Фабрика їжі» з метою перевірки виконання припису та усунення виявлених невідповідностей. Проведено повторні лабораторні дослідження змивів з об’єктів навколишнього середовища (обладнання, інвентар, посуд, виробничі столи та ін.).
Перевіркою встановлено усунення всіх невідповідностей, що є підставою для відновлення роботи їдальні ТОВ «Фабрика їжі».
Довідково:
Бактеріоносійство (застаріле - бацилоносійство) – перебування в організмі людини або тварини й виділення з нього збудників заразних захворювань без наявності видимих проявів хвороби.
Людина буває носієм збудників черевного тифу, паратифів, сальмонельозу, ешерихіозу, дифтерії, носієм стрептококів, стафілококів тощо.
Нагадаємо, прокуратура взяла під контроль хід розслідування масового отруєння.
Також варто додати, що у ході епідрозслідування встановлено, що спільними продуктами харчування для всіх потерпілих були салат «Дружба» (сирок плавлений, морква, грінки, часник, майонез), бульйон курячий з локшиною, гречка, ковбаски в соусі, хліб, чай.
Читайте також:
На Прикарпатті чоловік опинився у лікарні через отруєння грибами
























